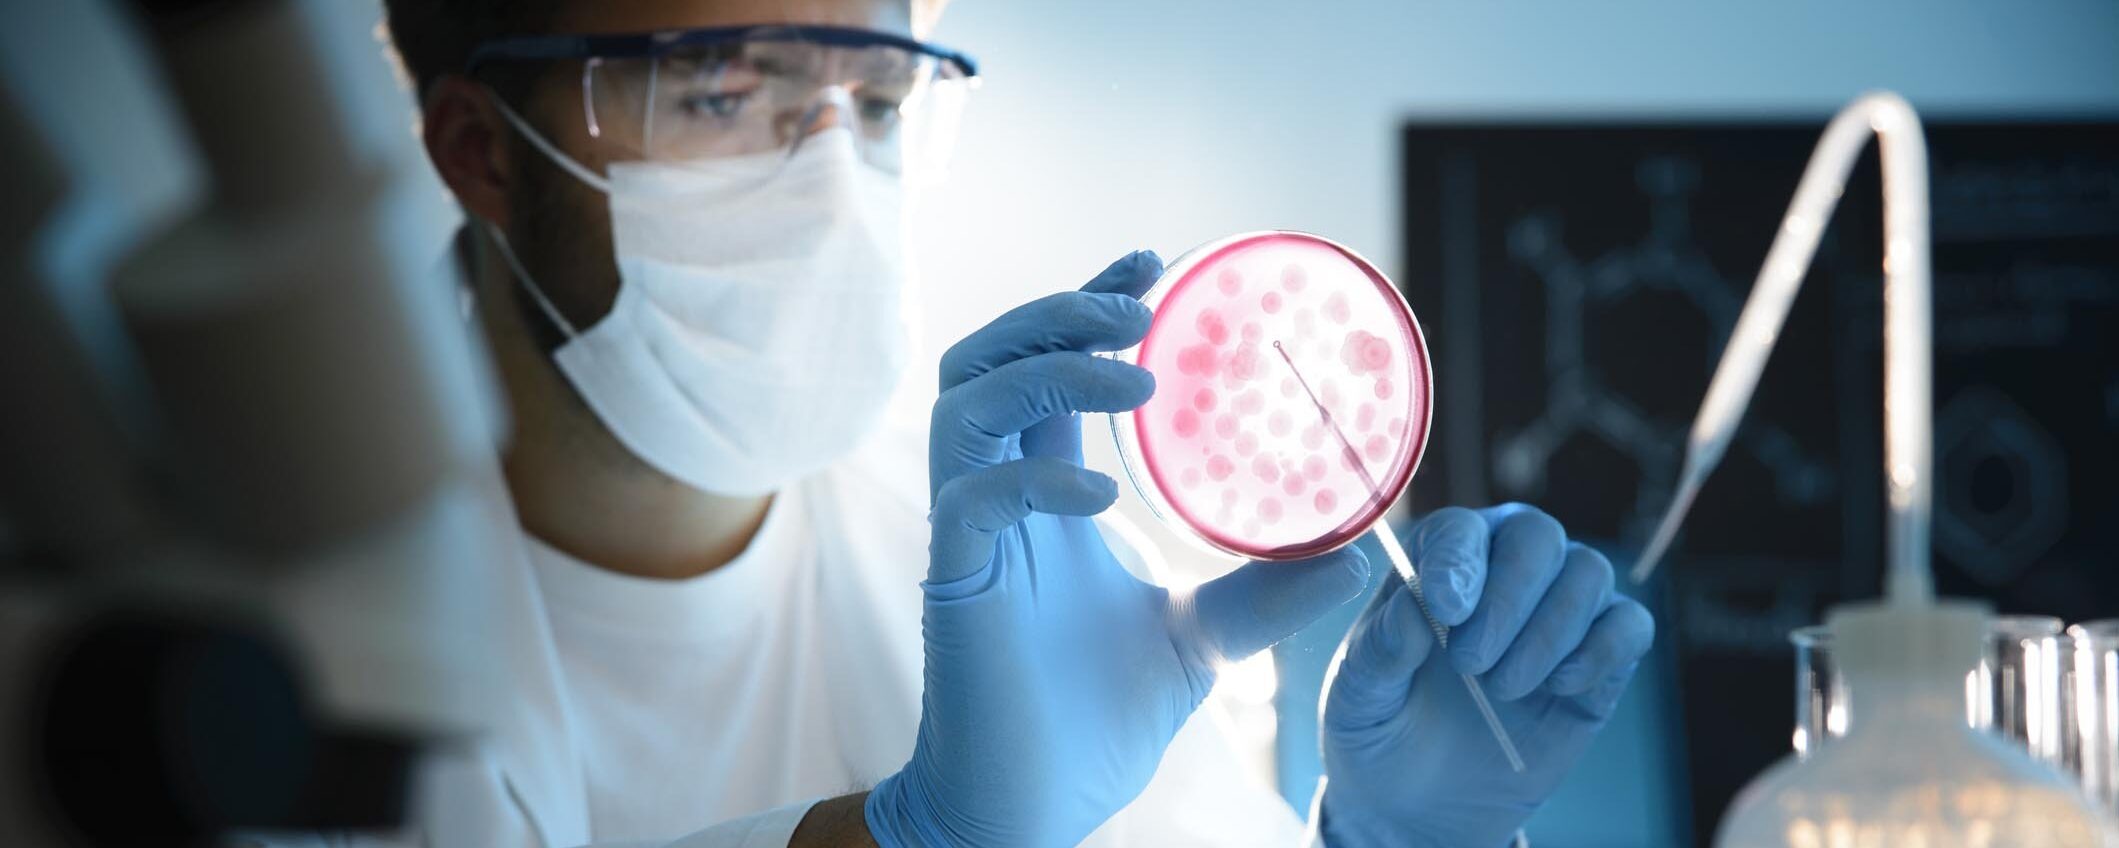

Leggi le notizie dell'Ultima Ora
La notizia che stai cercando non è aggiornata o non è più raggiungibile!
Wsj, Perplexity offre 34,5 miliardi per Chrome di Google quotidiano.net
Baldur’s gate 4 novità ufficiali da wizards of the coast jumptheshark.it
Scontro moto-furgone nel Mantovano, morto il carabiniere Mario Sicilia. Aveva frequentato la scuola allievi ... gazzettadelsud.it
Juventus Next Gen, Mancini è prossimo al trasferimento alla Virtus Verona! Formula e tempistiche dell’affare ... juventusnews24.com
Dal Multiverso ai nuovi X-Men, tutti i film MCU in uscita dopo I Fantastici 4: Gli Inizi comingsoon.it
Botulino killer, tutto quello che c’è da sapere: sintomi, intossicazione e cure panorama.it

Apple MacBook economico: tutto sul portatile da 599$ per studenti
Secondo fonti della catena di fornitura citate da DigiTimes, Apple starebbe per lanciare un MacBook... ► pantareinews.com

LIVE Bolelli/Vavassori Lammons/Pel, 6 4, 1 2 ATP Cincinnati 2025 in DIRETTA: la coppia azzurra si aggiudica il primo parziale con un brivido finale
CLICCA QUI PER AGGIORNARE LA DIRETTA LIVE 1-2 Game Lammons/Pel. Gioco che vola via rapido. Prima es... ► oasport.it

Elezioni regionali, Giani ha firmato il decreto: la Toscana al voto il 12 e il 13 ottobre
La Toscana al voto domenica 12 e lunedì 13 ottobre. Nella giornata di martedì 12 agosto il governa... ► livornotoday.it

Disservizi, attivo il nuovo servizio di segnalazioni online sul sito del Comune
Dopo un lungo periodo di inattività è ufficialmente ripartito il servizio per le segnalazioni di d... ► pordenonetoday.it

Erogazioni della Fondazione, ecco dove vanno i 5,3 milioni di euro della seconda sessione
Sono già 5,3 milioni di euro le risorse stanziate nel 2025 dalla Fondazione di Piacenza e Vigevano... ► ilpiacenza.it

Incidente con tamponamento in via Consolare Pompea, traffico nel caos sulla litoranea
Un tamponamento in via Consolare Pompea ha messo in crisi la viabilità. L'incidente che ha visto c... ► messinatoday.it

Pafos FC Dinamo Kiev (Qualificazioni Champions League, 12 08 2025 ore 19:00): formazioni ufficiali, quote, pronostici
Quando tutti si aspettavano la Dinamo Kiev di Shovkhovskyi il Pafos FC è andato nel finale a prende... ► infobetting.com

Demi Lovato e Joe Jonas: reunion a sorpresa per i fan di Camp Rock
Sul palco del MetLife Stadium, in New Jersey, la performance dei due cantanti (ed ex fidanzati) ha f... ► vanityfair.it

Ormeggi abusivi, ristoranti fantasma, lidi illegali: blitz fra Torre del Greco e Penisola Sorrentina
Sequestri, irregolarità, sanzioni: la Procura di Torre Annunziata al caccia dei lidi irregolari nel... ► fanpage.it

Giulia Bonin, il ricordo di chi le voleva bene: "Anima bella e fragile"
"Giulia lavorava, sognava di studiare all'università anche se era indecisa sulla facoltà. Era un'a... ► triesteprima.it

Demon slayer torna su shonen jump con un tributo speciale a black clover
celebrando il decennale di black clover: un tributo di artisti leggendari Il manga e anime Black Cl... ► jumptheshark.it

Giovedì l'ultimo saluto al motociclista di Loreggia
Saranno celebrati giovedì 14 agosto alle 10 nella parrocchia Purificazione Beata Vergine Maria di ... ► padovaoggi.it

“L’Italia in lutto per lui”. Chi era davvero Carlo, il bimbo morto annegato a sei anni
Il mare calmo di una domenica estiva si è trasformato in teatro di una tragedia che ha scosso un’in... ► caffeinamagazine.it

Calciomercato Milan: lo United aiuta il Diavolo con Hojlund. I dettagli
Calciomercato Milan: lo United aiuta il Diavolo con Hojlund. I dettagli sulla situazione legata all... ► calcionews24.com

Bonus psicologo 2025, via alle domande dal 15 settembre
Firenze, 12 agosto 2025 – Sempre più toscani si rivolgono a sedute di psicoterapia, complice l’aume... ► lanazione.it

Fuochi d'artificio, concerti ed eventi diffusi: Misano Adriatico di prepara al Ferragosto
Concerti, intrattenimento per tutta la famiglia e il grande spettacolo pirotecnico: la settimana d... ► riminitoday.it

Il controllore di volo diffonde via radio "Palestina libera". La compagnia israeliana: “Inappropriato”
I messaggi pro Palestina ora vengono lanciati anche quando si è a bordo di un aereo. Un controllore... ► iltempo.it

Leoni al Liverpool, spunta il retroscena sul giovane centrale difensivo: i Reds vogliono accelerare dopo i sondaggi di quei tre top club! Cosa filtra
di Redazione JuventusNews24Leoni al Liverpool, il club inglese ha deciso di non lasciarsi sfuggire l... ► juventusnews24.com

Dire wolf: l’ultima novità sulla de estinzione di khaleesi e dei suoi fratelli
progressi nella de-estinzione con colossal biosciences Colossal Biosciences continua a fare signifi... ► jumptheshark.it

Gallipoli, furto tra la folla al concerto: gioielli nascosti nel fermacapelli, coppia fermata nella notte
Coppia napoletana denunciata per ricettazione dopo furti con strappo durante un concerto a Gallipoli... ► virgilio.it

Perugia. Squarta: “Giorgia Meloni, una guida che incarna valori profondi. Il meglio deve ancora arrivare”
«Oggi non celebro un traguardo, ma una storia di forza, valore e visione». Con queste parole Marco ... ► laprimapagina.it

Gualtieri, cancel culture all’amatriciana: butta 800mila euro per cambiare i nomi delle fermate della metro C in salsa woke
Siamo in mano a un sindaco che gioca con i soldi dei romani. Fa rabbrividire lo stanziamento della... ► secoloditalia.it

Maranza in trasferta al mare strappano la collanina a 19enne bergamasco mentre fa il bagno a Riccione
Bergamo, 12 agosto 2025 – Scippo in mare a Riccione, dove domenica pomeriggio un ragazzo di 19 anni... ► ilgiorno.it

Sanità e liste d'attesa: firmato l'accordo da 123 milioni con i privati
Un accordo del servizio sanitario regionale con le strutture private accreditate per ridurre le li... ► triesteprima.it

Spenderemo altri 123 milioni di euro per farci curare da privati nel pubblico
Ci sono 14 milioni di euro in più rispetto al precedente accordo triennale per i privati che offro... ► udinetoday.it

Verbania: a Madonna di Campagna torna la Festa Alpina
Dal 13 al 17 agosto torna la Festa del Gruppo Alpini di Suna a Madonna di Campagna.Cucina aperta t... ► novaratoday.it

Napoli, controlli nei negozi di souvenir: scoperti lavoratori in nero
Controlli congiunti di Polizia Locale e Guardia di Finanza nei negozi di souvenir a Napoli: scoperti... ► 2anews.it

Dopo il raggiro in varie attività, nella casa spuntano 1000 euro in banconote false: una donna nei guai
Ieri pomeriggio i Carabinieri della stazione di Massa Lombarda hanno arrestato una 29enne della zo... ► ravennatoday.it

Trump Putin, Bruxelles placa i timori: “Prematuro parlare di un cattivo accordo”
Volodymyr Zelensky è intervenuto per ringraziare i vertici e i leader europei per il continuo e dur... ► ildifforme.it

Titolo Juve Borsa: quotazioni e info utili sulle azioni bianconere
di Redazione JuventusNews24Titolo Juve Borsa: Juventus FC è un club quotato in borsa. Ecco le inform... ► juventusnews24.com

Ben affleck e matt damon: il mistero dietro il town e la performance di jeremy renner
Il film The Town, diretto e interpretato da Ben Affleck, rappresenta uno dei suoi lavori più apprez... ► jumptheshark.it

Campagna di aglio, scalogno e cipolla: come è andata e le prospettive
La buona notizia è che i mercati per aglio, scalogno e cipolla piacentini, sono piuttosto favorevo... ► ilpiacenza.it

Roghi sul Vesuvio, i tre fronti di fuoco sono sotto controllo
In netto miglioramento la situazione sul Vesuvio, dove i tre fronti di fuoco sono, al momento, sotto... ► 2anews.it

Siena, concerto evento tra note e immagini al Palazzo delle Papesse
Siena, 11 agosto.2025 – Mercoledì 13 agosto alle ore 21.15, al Palazzo delle Papesse va in scena una... ► lanazione.it

«La nostra vicinanza alla famiglia del piccolo Carlo»: il cordoglio della comunità di Cavallino Treporti | VIDEO
Si è conclusa nel modo più tragico la lunga notte di ricerche per il piccolo Carlo Panizzo, sei an... ► veneziatoday.it

Film italiano sulla guerra che supera i libri di storia
un film che racconta la seconda guerra mondiale con equilibrio tra dramma e ironia Nel panorama cin... ► jumptheshark.it

Appello di Ghali agli artisti su Gaza: “E’ genocidio, incredibile non esporsi”
Ghali è tornato a parlare di Gaza e della causa palestinese, a partire dall’uccisione di sei giorna... ► lapresse.it

Trump contro Powell: “Tagli i tassi, valuto causa contro di lui”
Donald Trump torna ad attaccare Jerome Powell. Il presidente americano ha pubblicato un lungo post ... ► ilgiornale.it

Soresina, ai domiciliari ma la moglie lo caccia di casa e finisce in carcere
Soresina (Cremona), 12 agosto 2025 – Stava scontando la condanna in carcere con gli arresti domici... ► ilgiorno.it

Il vigile fuori servizio che trova e restituisce un portafoglio con 630 euro
Aveva perso il portafoglio con tutti i documenti, le carte di credito e 630 euro in contanti. Ma a... ► monzatoday.it

Viktoria Plzen Rangers (Qualificazioni Champions League, 12 08 2025 ore 19:00): formazioni ufficiali, quote, pronostici
I Rangers ripartono dalla vittoria per 3-0 nel match di andata che costringerà il Viktoria Plzen a ... ► infobetting.com
Botulino killer, tutto quello che c’è da sapere: sintomi, intossicazione e cure
Il botulismo è un’intossicazione alimentare rara ma estremamente pericolosa, provocata dalla tossin... ► panorama.it

Giorgia Rossi incanta Ponza: sole, mare e un look che spacca
Momenti di pura spensieratezza per Giorgia Rossi a Ponza: il suo look estivo e il sorriso contagios... ► ilveggente.it

La Notte Nel Cuore Anticipazioni Turche: Il Segreto Di Samet Viene A Galla!
Scopri come la rivelazione del figlio segreto di Samet Sansalan scuote le vite dei Sansalan: amori... ► uominiedonnenews.it

Luis Henrique Inter, è lui il vero enigma: il brasiliano può essere la vera arma in più di Chivu? L’analisi de La Repubblica
di RedazioneLuis Henrique Inter, il brasiliano può essere la vera arma in più di Chivu? Dubbi sulla ... ► internews24.com

Da star di Uomini e Donne a concorrente del Grande Fratello? Ecco chi è
Volto storico del Trono Over di Uomini e Donne, Giorgio Manetti ha lasciato il programma di Maria D... ► donnapop.it

“Il BIG in gara per la prima volta”, Carlo Conti punta in alto per Sanremo: il nome clamoroso
News tv. Dietro le quinte del Festival di Sanremo 2026 si respira un’atmosfera carica di aspettativ... ► tvzap.it

La Cassazione apre ai patti pre divorzio: “Valido l’accordo economico tra coniugi in vista di un’eventuale separazione”
La Corte di Cassazione apre ai patti sottoscritti tra coniugi o futuri coniugi per regolare gli asp... ► ilfattoquotidiano.it

Juventus Next Gen, arriva Okoro: colpo in prospettiva. In uscita Facundo e Rouhi
Mentre il mercato della Juventus resta bloccato sul fronte delle grandi operazioni, la dirigenza bi... ► stilejuventus.com

‘Nuova Cusano’ attacca l’amministrazione Crocco: “Trasparenza negata, da tre mesi il sindaco blocca l’accesso al protocollo”
Tempo di lettura: 2 minutiIl gruppo consiliare di minoranza ‘Nuova Cusano’ denuncia pubblicamente ... ► anteprima24.it

Roma, per il bosco di Pietralata relazione tecnica: “Scarso valore naturalistico”
Il dipartimento Tutela Ambientale acquisisce la perizia dell’agronomo Mauro Uniformi sulle aree int... ► romadailynews.it

Terrore in riviera: spari con pistola a pallini contro passanti, fermati
Pescara - Una serie di “giochi” pericolosi con pistola ad aria compressa ha spettinato l’estate tra... ► abruzzo24ore.tv

Scappa dall’Rsa e muore in ospedale, la Procura apre un'inchiesta per omicidio colposo
L’anziano di 89 anni con diverse patologie acclarate, nonostante la vigilanza è riuscito qualche gi... ► ilsecoloxix.it

Big bang theory: come il successo di stuart ha dimostrato la forza degli spin off
Il panorama delle produzioni televisive legate a “The Big Bang Theory” si sta ampliando con nuovi p... ► jumptheshark.it

Modena, trovato morto psicologo Raffaele Marangio con una cintura al collo nella sua abitazione: aperta indagine per omicidio
Il corpo di Raffaele Marangio, 78 anni, noto psicologo e psicoterapeuta, è stato rinvenuto lo scor... ► ilgiornaleditalia.it

Wsj, Perplexity offre 34,5 miliardi per Chrome di Google
La startup per l'intelligenza artificiale Perplexity ha offerto 34,5 miliardi di dollari per acquist... ► quotidiano.net

Golden hour a San Miniato
Il 26 agosto 2025 alle ore 19:00 appuntamento a San Miniato per un evento speciale che unisce stor... ► pisatoday.it

Mal di schiena: cosa possono fare davvero i massaggi?
Quando la schiena inizia a sentirsi tesa, il nostro primo istinto è spesso lo stesso: farsi fare un... ► ilgiornale.it

Tragedia al lago: giovane studente tunisino muore in un attimo fatale
L'Aquila - Un ventunenne tunisino si tuffa nel lago Sinizzo durante una gita con amici, ma una prob... ► abruzzo24ore.tv

Emily in Paris sbarca a Venezia, il ‘caso casting’: come devono essere le comparse
(Adnkronos) – Emily in Paris sbarca a Venezia per le riprese della quinta stagione. E la Laguna si p... ► periodicodaily.com

Pirates of the Caribbean 6: nuove speranze per il ritorno di Johnny Depp
Il futuro della celebre saga piratesca si sta delineando con alcuni segnali promettenti riguardo al... ► jumptheshark.it

FC Copenaghen Malmo (Qualificazioni Champions League, 12 08 2025 ore 19:00): formazioni ufficiali, quote, pronostici
Lo 0 a 0 della gara d’andata e le poche occasioni viste a Malmo danno l’idea della partita a scacch... ► infobetting.com